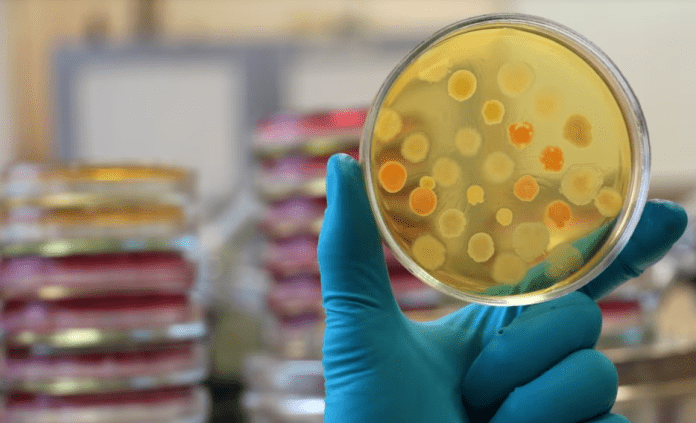
ETHE

Autoritetet shëndetësore në Maqedoninë e Veriut theksojnë se nuk ka vend për panik nga infeksioni i shkaktuar nga pickimi i rriqrave, që njihet si ethet hemorragjike – krime kongo.
Ata sqarojnë se kjo sëmundje është e rrallë dhe shumë vështirë transmetohet përmes kontaktit të drejtpërdrejtë me personat e infektuar.
Shqetësimi nga shfaqja e etheve hemorragjike është rritur pas vdekjes së një gruaje 27-vjeçare nga një fshat i Shtipit (qytet në lindje të Maqedonisë së Veriut), më 27 korrik, si pasojë e pickimit nga rriqra.
Ndërkohë, në spitalin e Infektologjisë qe më shumë se një javë është duke u kuruar një paciente e personelit mjekësor, që është infektuar derisa përkujdesej për 27-vjeçaren.
Gjendja shëndetësore e punonjëses së shëndetësisë është e qëndrueshme, theksojnë nga Klinika e Infektologjisë.
“Është bërë anketë epidemiologjike për pacienten, nga ku kemi kuptuar se ajo është pickuar nga një rriqër që është hequr në kushte shtëpiake. Pas paraqitjes së simptomave (disa ditë pas pickimit) fillimisht është shtruar në spital në Shtip, më
pas në Shkup”, kanë theksuar nga Inspektorati Shtetëror Sanitar dhe Shëndetësor.
Nga ky institucion bëjnë të ditur se tashmë kanë vënë nën mbikëqyrje 40 persona që kanë pasur kontakt me viktimën, që të parandalohet përhapja e etheve hemorragjike.
“Nën mbikëqyrje shëndetësore vendosen personat që kanë pasur kontakt me personat që kanë shfaqur simptoma të kësaj sëmundjeje. Ata zakonisht vendosen nën mbikëqyrje shëndetësore për t’i mbrojtur njerëzit që mund të jenë të sëmurë, si dhe për t’i mbrojtur ata që mund të transmetojnë sëmundjen”, bën të ditur imunologu Mirko Spiroski, themelues i Institutit për Imuno-biologji dhe Gjenetikë Humane.
Ai thekson për Radion Evropa e Lirë se kjo sëmundje në Maqedoninë e Veriut është shumë e rrallë.
“Qytetarët tashmë janë informuar se mënyra kryesore e transmetimit të virusit është nëpërmjet pickimit të rriqrës te një person dhe futja e virusit nga rriqrat në trupin e njeriut, ku infeksioni përhapet në të gjithë trupin. Megjithatë, transmetimi nga njeriu te njeriu ndodh vetëm duke rënë në kontakt me lëngjet trupore që përmbajnë virusin. Në mbi 99 për qind të rasteve që preken nga kjo sëmundje përmes kontaktit të drejtpërdrejtë, janë punonjësit shëndetësorë, gjatë kontaktit të drejtpërdrejtë me personat e infektuar”, shpjegon Spiroski.
Nga dikasteri i shëndetësisë rikujtojnë se infeksioni na ethet hemorragjike nga pickimi i rriqrave përcillet me dhimbje koke, temperaturë të lartë, dhimbje në shpinë, kyçe, stomak dhe të vjella.
Me përparimin e sëmundjes, në trupin e pacientit shfaqen mavijosje, si dhe gjakderdhje nga hunda. Rikuperimi është i ngadaltë.
Nga ky dikaster theksojnë se kjo sëmundje është serioze me vetë faktin se shkalla e vdekshmërisë nga ethet hemorragjike është shumë e lartë, ndërsa bëjnë thirrje
që në rast se pickohen nga rriqrat, të kërkohet menjëherë ndihma e mjekut pasi vonesat në trajtimin e rasteve mund të rezultojnë fatale./REL